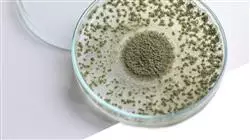
##IMAGE##

Университетская квалификация
Крупнейшая в мире школа питания”
Презентация
Благодаря этому Университетскому курсу вы сможете наиболее эффективно оценивать и управлять результатами проекта’’

Защита и передача результатов исследований, несомненно, важны для получения экономических и социальных выгод. Действительно, научные достижения могут оказать значительное влияние на все сферы жизни, создавая рабочие места, повышая качество жизни и решая глобальные проблемы, такие как проблемы, связанные с привычками питания. В этом смысле защита интеллектуальной собственности имеет решающее значение для контроля за использованием технологий и поощрения инноваций. С другой стороны, передача результатов исследований позволяет перенести научные открытия из лаборатории на рынок, чтобы ими могло воспользоваться все общество.
По этой причине специалисты в области питания должны следить за определенными стратегиями, которые защищают их результаты от потенциальных угроз. Именно поэтому данная программа - идеальная возможность, благодаря строгому подходу, который позволит диетологам получить новые знания о патентах и оценке результатов исследований. С этой целью студенты будут углублять знания в правильном использование, обмене и хранении этих результатов. Кроме того, они обратят особое внимание на ключевые понятия в этой области, такие как промышленная тайна или договор о передаче технологии.
Вся эта ценная подготовка будет обеспечена командой образцовых преподавателей, чьи профили находятся в на передовой отрасли, что гарантирует, что студенты получат самое лучшее образование. Помимо этого, TECH предлагает инновационную методику обучения, адаптированную к современности, с аудиовизуальным контентом и различными интерактивными форматами.
Получите необходимую подготовку высокого уровня по всем аспектам защиты результатов, процессов и идей в секторе питания и станьте экспертом в этой области"
Данный Университетский курс в области защиты и передачи результатов медицинских исследований содержит самую полную и современную научную программу на рынке. Основными особенностями обучения являются:
- Разбор практических кейсов, представленных экспертами в области защиты и передачи результатов научных исследований
- Наглядное, схематичное и исключительно практическое содержание курса предоставляет научную и практическую информацию по тем дисциплинам, которые необходимы для осуществления профессиональной деятельности
- Практические упражнения для самооценки, контроля и улучшения успеваемости
- Особое внимание уделяется инновационным методологиям
- Теоретические занятия, вопросы эксперту, дискуссионные форумы по спорным темам и самостоятельная работа
- Учебные материалы курса доступны с любого стационарного или мобильного устройства с выходом в интернет
TECH облегчает вам задачу: защитите свои результаты гарантиями с помощью патентов, оценив их плюсы и минусы"
В преподавательский состав программы входят профессионалы из данного сектора, которые привносят в обучение опыт своей работы, а также признанные специалисты из ведущих сообществ и престижных университетов.
Мультимедийное содержание программы, разработанное с использованием новейших образовательных технологий, позволит специалисту проходить обучение с учетом контекста и ситуации, т.е. в симулированной среде, обеспечивающей иммерсивный учебный процесс, запрограммированный на обучение в реальных ситуациях.
Структура этой программы основана на проблемно-ориентированном обучении, с помощью которого специалист должен попытаться разрешать различные ситуации из профессиональной практики, возникающие в течение учебного курса. В этом студенту поможет инновационная интерактивная видеосистема, созданная признанными экспертами.
Если вы искали программу, которая могла бы повлиять на создание компаний спин-офф в результате исследовательского проекта, то это ваш шанс"
Хотите овладеть всеми аспектами коммерческой тайны? Вы находитесь всего в 180 часах от этого!"
Учебный план
Все содержание Университетского курса в области защиты и передачи результатов медицинских исследований подготовлено профессионалами из разных отраслей. В рамках этого курса рассматриваются все аспекты, необходимые диетологу в его исследовательской практике: от знаний о защите данных до создания спин-офф компаний. Все это предлагается в различных интерактивных форматах, которые сделают образовательный цикл гораздо более динамичным.

Учебный план, сжатый до 6 недель обучения, который не оставляет без внимания ни одной ключевой концепции в защите и передаче результатов"
Модуль 1. Защита и передача результатов
1.1. Защита результатов: Общие сведения
1.2. Оценка результатов исследовательского проекта
1.3. Патенты: за и против
1.4. Другие формы защиты результатов
1.5. Передача результатов в клиническую практику
1.6. Передача результатов в промышленность
1.7. Контракт на передачу технологии
1.8. Промышленная тайна
1.9. Создание спин-офф компаний в рамках исследовательского проекта
1.10. Поиск инвестиционных возможностей в спин-офф компаниях

С помощью Relearning вы успешно усвоите новейшие стратегии передачи результатов в клиническую практику"
Университетский курс в области защиты и передачи результатов медицинских исследований
В мире, где исследования в области питания играют фундаментальную роль в улучшении здоровья и благополучия людей, очень важно обладать необходимыми навыками для управления и защиты ценных результатов таких исследований. TECH Технологический университет предлагает вам уникальную возможность освоить эту область с помощью нашего Университетского курса в области защиты и передачи результатов медицинских исследований в сфере питания. Занятия по этой программе в режиме онлайн позволят вам совершенствовать свои знания, не отрываясь от текущих дел. Теперь вы можете получать доступ к обучению из любого места и в любое удобное для вас время. Такой способ обучения позволит вам сбалансировать свои профессиональные и личные обязанности, погружаясь в мир управления результатами исследований в области питания.
Отличитесь в управлении медицинскими результатами в области питания
TECH Технологический университет с гордостью представляет программу, направленную на удовлетворение практических потребностей профессионалов в области питания. Благодаря этому курсу вы познакомитесь со стратегиями и инструментами, необходимыми для эффективной защиты и передачи результатов ваших исследований. Вы не только узнаете о передовых методах управления интеллектуальной собственностью и данными, но и приобретете способность эффективно доносить свои результаты с помощью убедительных отчетов и презентаций. Почему стоит выбрать этот курс? Преимущества очевидны и неоспоримы. По мере прохождения программы вы приобретете компетенцию, необходимую для защиты результатов ваших исследований и оптимизации их влияния на сферу питания. Вы научитесь переводить данные в практическую плоскость и эффективно сотрудничать с коллегами и заинтересованными сторонами. TECH Технологический университет предоставляет вам исключительную платформу обучения, разработанную для вдохновения и расширения возможностей профессионалов, стремящихся преуспеть в управлении результатами исследований в области медицинского питания. Присоединяйтесь к этой программе и приобретите навыки, которые позволят вам изменить ситуацию в области укрепления здоровья и благополучия с помощью исследований в области питания.







